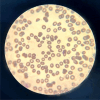

The influence of sepsis on erythrocytes morphology: case report and literature review
- PMID: 38527992
- PMCID: PMC11146462
- DOI: 10.47162/RJME.65.1.15
The influence of sepsis on erythrocytes morphology: case report and literature review
Abstract
This paper highlights a clinical case of sepsis caused by soft tissue infection. Peripheral blood smear, plasma value of inflammatory biomarkers and the white blood cells count were performed. Significant morphological changes were revealed through peripheral blood smear test two days after patient admission. Patient developed septic shock after the third day in intensive care unit (ICU). Laboratory results showed major morphological changes (erythrocytes deformity, abnormal neutrophils); these were correlated with elevated plasma value of interleukin-6 and procalcitonin.
Conflict of interest statement
The authors declare that they have no conflict of interests. The authors are responsible for the content and writing of the papers.
Figures

References
-
- Singer M, Deutschman CS, Seymour CW, Shankar-Hari M, Annane D, Bauer M, Bellomo R, Bernard GR, Chiche JD, Coopersmith CM, Hotchkiss RS, Levy MM, Marshall JC, Martin GS, Opal SM, Rubenfeld GD, van der, Vincent JL, Angus DC. The Third International Consensus definitions for sepsis and septic shock (Sepsis-3) JAMA. 2016;315(8):801–810. - PMC - PubMed
-
- Ellis CG, Bateman RM, Sharpe MD, Sibbald WJ, Gill R. Effect of a maldistribution of microvascular blood flow on capillary O2 extraction in sepsis. Am J Physiol Heart Circ Physiol. 2002;282(1):H156–H164. - PubMed
-
- Nicolescu LC, Nicolescu CM, Mihu AG, Balta C. The effect of red blood cell transfusion on peripheral tissue oxygen delivery and consumption in septic patients. Transfus Clin Biol. 2021;28(1):5–10. - PubMed
Publication types
MeSH terms
Substances
LinkOut - more resources
Full Text Sources
Medical

